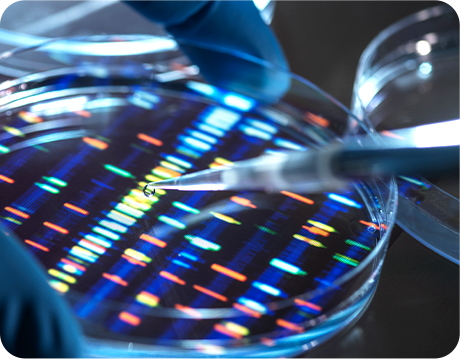
Scientific Integrity
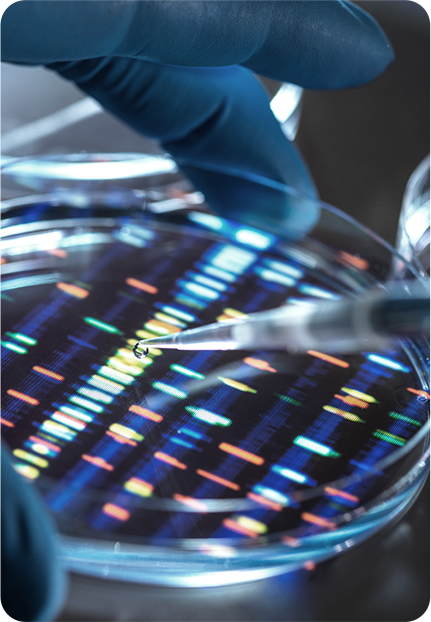
Scientific Integrity

과학적으로 검증된 접근으로,
세포 수준에서 당신의 건강을 설계합니다
세포 활력의 설계자 
THE ROOT OF HEALTH





DR.ROOTEM • BRAND FILM
과학적으로 검증된 솔루션으로
당신만의 건강을 설계합니다.
닥터루템은 능동적 건강 관리의 기준을
새롭게 정의합니다.
과학적으로 검증된 고효능 솔루션을 통해,
모든 사람이 개인이 세포 건강을 기반으로
자신의 건강을 스스로 설계하고 관리하도록 돕습니다.
과학적 무결성

능동적 웰니스

이해하기 쉬운 전문성
과학적 무결성
닥터루템은
검증 가능한 연구와 데이터를 기준으로
제품을 설계합니다.
성분, 함량, 기전, 효능에 대한
모든 커뮤니케이션은
근거 기반(Evidence-based) 원칙
위에서만 이루어집니다.
불확실한 과장과 모호한 암시로
믿음을 얻는 대신,
투명한 기준과 검증 프로세스로
신뢰를 다시 세웁니다.
'닥터'라는 이름이 의미하는 책임에 걸맞게,
오로지 과학적 증명으로
당신을 위한 건강 설계 시스템을
구축합니다.

능동적 웰니스
닥터루템은
단기적 문제 해결에 머무르지 않습니다.
오늘의 컨디션을 끌어올리는 것을 넘어,
내일의 건강 리스크를 줄이는 생활 기반의
웰니스를 지향합니다.
지속 가능한 습관을 만들고,
작은 변화를 누적시키며,
내 몸의 기준을 높이는 것
닥터루템은 그 과정을 더 쉽고,
더 현실적으로 만들기 위해 존재합니다.
'필요할 때만 찾는 솔루션'이 아닌,
매일의 생활 속에 자연스럽게 들어오는
웰니스 전략을 당신에게 제안합니다.

이해하기 쉬운 전문성
닥터루템은
복잡한 과학을 소비자가 이해하고
일상에서 바로 적용 가능한 형태로
명확하게 번역합니다.
무엇을 선택해야 하는지보다 더 중요한 것은,
왜 그 선택이 합리적인지를
스스로 이해하는 것입니다.
우리는 당신이
자기 몸의 의사결정을 하는 사람
이 되도록 돕습니다.
성분표를 읽는 순간부터,
일상 속 루틴을 만드는 과정까지
실행 가능한 가이드로 제공하는 것,
그것이 우리의 전문성입니다.




90세까지 '평생 현역'으로 살아온 삶 자체가 저속노화의 해답입니다.
이시형 박사는 뇌 건강, 세로토닌, 면역 균형처럼
신체와 정신을 함께 다루는 총체적 건강 관리를 제시합니다.
단순한 장수의 기술이 아니라, 과학적 근거 위에서
건강수명을 길게 설계하는 원리와 습관을 전합니다.
성별이나 교정된 기준에 건강을 가두지 않습니다.
장진석 박사는 운동과 활동적인 삶을 사랑하는 누구나
자신의 퍼포먼스를 확장할 수 있도록 에너지 대사, 근육 회복 등
당신의 컨디션 최적화 관점의 전략을 설계합니다.
매일의 체력을 '유지'하는 수준을 넘어,
삶의 출력 자체를 높이는 실행 중심의 솔루션을 제시합니다.
아름다움은 감이 아니라 근거로 완성됩니다.
비만, 영양학 전문가 김윤근 박사는
내면의 건강이 외면의 컨디션과 인상으로 이어지는
연결고리를 과학적으로 쓸어냅니다.
피부 세포 건강, 항산화 균형, 영양 기반 설계를 통해
꾸미는 아름다움이 아니라 '지속되는' 이너뷰티를 제안합니다.
건강한 삶은 흔들리지 않는 기본기에서 시작됩니다.
오랜 시간 무대 위에서 컨디션을 유지해 온 가수 남진처럼,
'롱런'의 핵심은 결국 매일 쌓이는 바탕입니다.
닥터루템 에센셜은 '무엇을 더하느냐'보다,
'무엇을 제대로 채우느냐'에 집중합니다.
남진의 무대가 하루아침에 만들어지지 않듯,
건강도 매일의 기본이 쌓여 완성되니까요.

보호 · 안정
육각 구조와 겹겹이 둘러싼 라인은
자연계의 안정성을 상징,
세포 구조를 견고하게 유지하고
유해한 외부자극으로부터
보호하는 방패의 역할

상승 · 에너지
위로 치솟는 삼각형은 전성기를 향해
가속하는 폭발적 에너지와 도약을 상징,
당신의 퍼포먼스 향상을 위한
성장과 발전 그리고 목표를 향한
강한 의지를 상징

순수 · 본질
우리 몸에 꼭 필요한 순수한 영양과
아름다움의 정수를 한 방울에 응축
물방울 형태는
촉촉함과 생기를 상징하며,
몸 속부터 차오르는 수분감을 시각화

균형 · 조화
인피니트 루프는 비타민·미네랄 등
필수 영양소 간의 연결과 시너지를 상징,
모서리 없는 원의 흐름으로
에너지의 순환과 유연한 균형이
웰빙을 완성함을 상징




